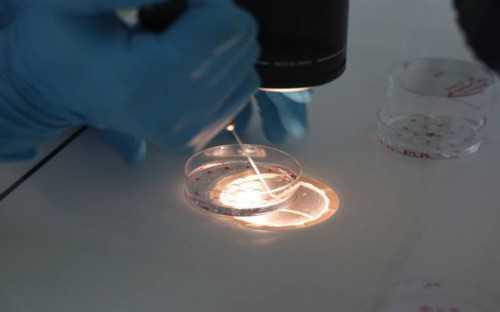
正规试管代孕公司,孕期能用黛珂牛油果乳液吗！附助孕价格表！

孕期可以使用 Décolletage 牛油果乳液吗?敏感性皮肤的孕妇可以在孕期使用吗?皮肤敏感的孕妇可以在怀孕期间使用 Dekker 的樱花果水霜。准确地说,德克的牛油果乳液一般都是和紫苏水一起使用的,保湿乳液的成分是安全的,关键是天然植物精华,不存在孕妇敏感的成分,再加上保湿乳液质地非常清爽湿润,不仅不会对皮肤造成特别大的压力,还能满足皮肤保湿工作的需要,所以即使是敏感肌肤的孕妇也是可以使用的。
女性在怀孕之后,由于自身内分泌的变化,会出现一系列的孕吐反应。有些孕妇在脸部出现反应时,会发现皮肤比以前更干燥了。因此,孕期保湿滋润也非常重要。Dirk's Shiso Water释迦水乳霜是大家的最爱。很多孕妇都非常关心它是否适合孕妇使用:
医生你好,我已经怀孕三个月了。怀孕后,我发现面部皮肤明显干燥。另外,现在天气很热,我的皮肤快要裂开了。我家里的 Dekker 紫苏水和牛油果乳液也不够用。我可以在怀孕期间使用它们吗?
怀孕期间可以使用紫苏水和牛油果乳液。这两种产品的主要成分都是天然提取物,没有添加孕妇禁用的化妆品成分。
我以前看到过怀孕妈妈使用戴克的护肤品长痘痘。这是产品问题还是其他原因?我怎样才能避免这种情况发生?
因为戴克不是专门的孕期护肤品,所以有些孕妇可能会出现一些不良反应。如果想预防此类事情的发生,建议孕妇在怀孕初期就选择孕期专用的护肤品。
备孕三个月时,女性尽量不要添加任何护肤品和化妆品。孕中期以后,可以根据自身情况购买孕期专用护肤品,但建议准妈妈做好基础护肤工作。